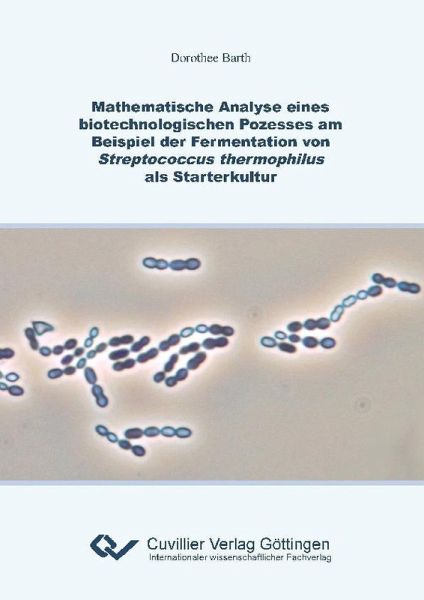
Mathematische Analyse eines biotechnologischen Prozesses am Beispiel der Fermentation von Streptococcus thermophilus als Starterkultur (eBook, PDF) Mathematische Analyse eines biotechnologischen Prozesses am Beispiel der Fermentation von Streptococcus thermophilus als Starterkultur (eBook, PDF)

Mathematische Analyse eines biotechnologischen Prozesses am Beispiel der Fermentation von Streptococcus thermophilus als Starterkultur (eBook, PDF)
Sofort per Download lieferbar
Statt: 32,95 €**
23,07 €
inkl. MwSt. und vom Verlag festgesetzt.
**Preis der gedruckten Ausgabe (Broschiertes Buch)
Alle Infos zum eBook verschenkenWeitere Ausgaben:
PAYBACK Punkte
0 °P sammeln!
Der industrielle Prozess zur Kultivierung von Streptococcus thermophilus als Starterkultur der Milchindustrie ist noch immer gekennzeichnet durch traditionelle Prozessverläufe, heuristische Optimierungsmethoden und manuelle Prozesssteuerung. Um moderne und innovative Methoden der Prozessentwicklung und -regelung anwenden zu können, ist ein mathematisches Modell dieses Systems notwendig. Die Analyse des Kultivationsprozesses von Streptococcus thermophilus zeigt, dass die Dynamik durch die drei Systemzustände Keimzahl, Konzentration des Substrats Lactose sowie des Produkts Lactat bestimmt wir...
Der industrielle Prozess zur Kultivierung von Streptococcus thermophilus als Starterkultur der Milchindustrie ist noch immer gekennzeichnet durch traditionelle Prozessverläufe, heuristische Optimierungsmethoden und manuelle Prozesssteuerung. Um moderne und innovative Methoden der Prozessentwicklung und -regelung anwenden zu können, ist ein mathematisches Modell dieses Systems notwendig. Die Analyse des Kultivationsprozesses von Streptococcus thermophilus zeigt, dass die Dynamik durch die drei Systemzustände Keimzahl, Konzentration des Substrats Lactose sowie des Produkts Lactat bestimmt wird. Das Prozessmodell setzt sich somit aus Differentialgleichungen zur Beschreibung dieser drei Systemzustände zusammen. Das wichtigste Qualitätsmerkmal einer Starterkultur ist ihre Säuerungsaktivität. Durch eine mathematische Beschreibung der Aktivität in Abhängigkeit der Lactatproduktionsrate ist es möglich, diese Eigenschaft in das mathematische Modell zu integrieren. Die Parameteridentifikation wird durch einen Hybrid aus Genetischem Algorithmus und Downhill-Simplex durchgeführt. Dieser Hybrid ist in der Lage, das Problem der Parameterschätzung trotz Nichtlinearitäten des Modells, Messrauschen und Parameterkorrelationen robust und automatisiert zu lösen. Die Modellstruktur lässt sich auf Prozesse mit veränderten Prozessparametern, auf weitere Stämme des Bakteriums Streptococcus thermophilus und auf Fed-Batch Experimente übertragen. Die Parameterschätzmethode gibt dabei verlässliche Ergebnisse, ohne dass der Algorithmus dem Problem neu angepasst werden muss. Das Modell in Verbindung mit der Parameterschätzmethode ermöglicht damit die Anwendung moderner Verfahren der Regelungstechnik und Prozessoptimierung auf die Herstellung von Streptococcus thermophilus als Starterkultur.
Dieser Download kann aus rechtlichen Gründen nur mit Rechnungsadresse in A, B, BG, CY, CZ, D, DK, EW, E, FIN, F, GR, HR, H, IRL, I, LT, L, LR, M, NL, PL, P, R, S, SLO, SK ausgeliefert werden.